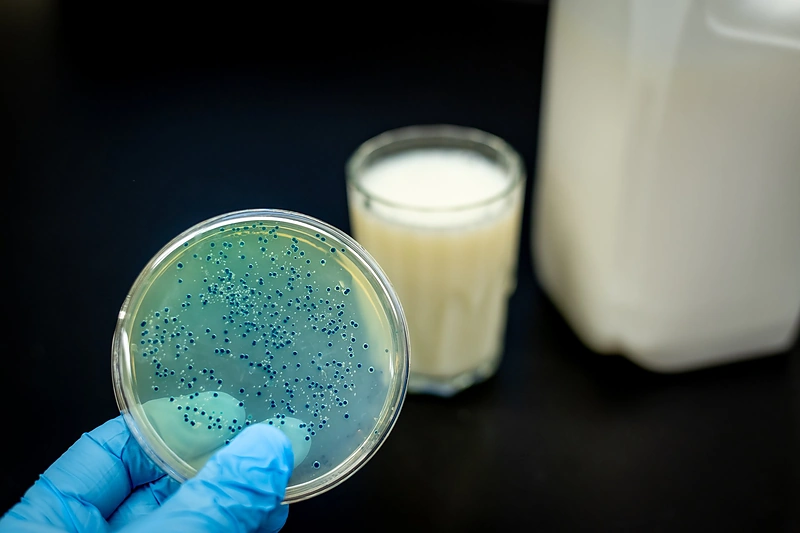
Kas yra postbiotikai ir kodėl jie svarbūs? / „Acorus Balance“ nuotr.

Kas yra postbiotikai ir kodėl jie svarbūs?

Papildomai vartojamos gerosios bakterijos, arba PRO-biotic, patekusios į virškinimo traktą, turi atlaikyti skrandžio rūgšties, virškinimo fermentų ir kitų nepalankių veiksnių poveikį, kad, nukeliavusios į storąją žarną, ten apsigyventų ir pradėtų daugintis. Jei gerosios bakterijos neišgyvens, papildomas jų vartojimas neduos norimos naudos organizmui.
Gerosios bakterijos turi ne tik ištverti kelionę per virškinimo traktą, bet pasiekus tikslą (storąją žarną), įsitvirtinti, sėkmingai kovoti su blogosiomis bakterijomis, išgyventi ir pradėti daugintis. Tam gerosios bakterijos turi gauti pakankamą kiekį maisto, tiksliau – maistinių skaidulų, dar vadinamų PRE-biotic. Kaip ir kiekvienas organizmas, negavęs maisto, gerosios bakterijos neišgyvens ir nesidaugins.
Jei gerosioms bakterijoms pavyksta sėkmingai įsitvirtinti ir daugintis, jos savo gyvenimo cikle išskiria medžiagų apykaitos produktus – postbiotikus. Šios medžiagos, kurias išskiria gerosios bakterijos, apima trumpųjų grandinių riebalų rūgštis, peptidus ir fermentus. Jų kiekis ir lemia gerųjų bakterijų teigiamą poveikį organizmui, kurio mes siekiame vartodami gerąsias bakterijas.
Maisto papildo Pre-Pro-Post-biotic sudėtyje jau yra unikalių, gyvų bakterijų pagamintų postbiotikų (Fibriotics®), todėl galima nesibaiminti, kad suvartotos gerosios bakterijos neišgyvens (keliaudamos per virškinimo traktą), nes iš karto su maisto papildu yra gaunami bakterijų pagaminti postbiotikai.
Kaip gaminami postbiotikai Fibriotics®?
Specialiuose bioreaktoriuose gyvąsias Lacto ir Bifido bakterijas pamaitinus 36 rūšių vaisiais ir daržovėmis, jos pasitelkia unikalius fermentacijos procesus ir pagamina postbiotikus, kurie yra išgryninami ir tampa produkto sudėtine dalimi.
Fermentacijai naudojami obuoliai, morkos, šilkmedžių uogos, ananasai, ridikėliai, citrinos, apelsinai, burokėliai, slyvos, džiovintos slyvos, pasifloros, arbūzai, erškėčiai, acerolos (kraštūtosios malpigijos), smidrai, bananai, mėlynės, juodieji serbentai, brokoliai, vyšnios, aronijos, spanguolės, agrastai, vynuogės, greipfrutai, gudobelės, datulės, ličiai, melionai, papajos, persikai, kriaušės, granatai, avietės, braškės ir pomidorai.
Be to, produkto sudėtyje esančios maistinės skaidulos (PRE-biotic), kartu su postbiotikais, padeda gerosioms bakterijoms geriau išgyventi žmogaus virškinimo trakte, kovoti su blogosiomis bakterijomis, įsitvirtinti žarnyne ir pradėti daugintis, kas nulemia ilgalaikį produkto poveikį.
Postbiotikų, gerųjų bakterijų, skaidulų galima gauti valgant fermentuotus vaisius ir daržoves, pavyzdžiui, raugintus agurkus, kopūstus, rauginto pieno produktus ir kitus. Tačiau ne kiekvienas geba į kasdienį mitybos racioną įtraukti šiuos produktus, o juo labiau – kelias skirtingas rūšis.
Pre-Pro-Post-biotic – tai unikalūs naujos kartos maisto papildai, kurių sudėtyje yra gerųjų bakterijų, jų maisto ir apykaitos produktų – postbiotikų, kurių kiekis teigiamai veikia organizmą ir padeda pasiekti norimą sveikatos poveikį vartojant gerąsias bakterijas.

+2